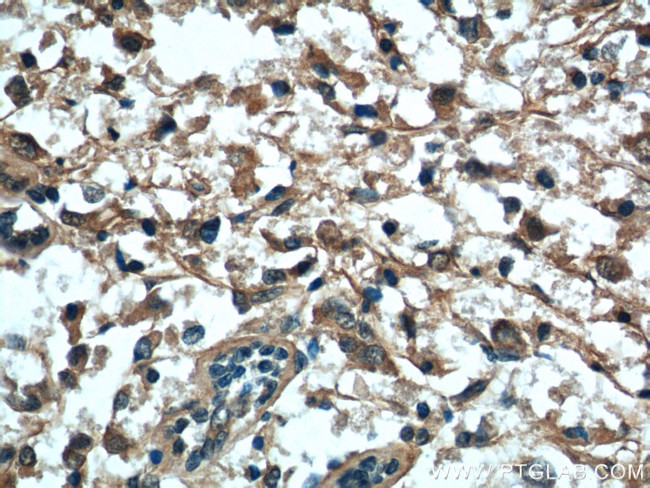
VTCN1 Antibody in Immunohistochemistry (Paraffin) (IHC (P))

Search
Proteintech
VTCN1 Polyclonal Antibody
{{$productOrderCtrl.translations['antibody.pdp.commerceCard.promotion.promotions']}}
{{$productOrderCtrl.translations['antibody.pdp.commerceCard.promotion.viewpromo']}}
{{$productOrderCtrl.translations['antibody.pdp.commerceCard.promotion.promocode']}}: {{promo.promoCode}} {{promo.promoTitle}} {{promo.promoDescription}}. {{$productOrderCtrl.translations['antibody.pdp.commerceCard.promotion.learnmore']}}
产品信息
12080-1-AP
种属反应
已发表种属
宿主/亚型
分类
类型
抗原
偶联物
形式
浓度
规格
纯化类型
保存液
内含物
保存条件
运输条件
产品详细信息
Immunogen sequence: MFRGRTAVF ADQVIVGNAS LRLKNVQLTD AGTYKCYIIT SKGKGNANLE YKTGAFSMPE VNVDYNASSE TLRCEAPRWF PQPTVVWASQ VDQGANFSEV SNTSFELNSE NVTMKVVSVL YNVTINNTYS CMIENDIAKA TGDIKVTESE IKRRSHLQLL NSKASLCVSS FFAISWALLP LSPYLMLK (1-187 aa encoded by BC065717)
靶标信息
B7-H4 (B7x, VTCN1) a costimulatory protein which is reported to function as a negative regulator of T-cell mediated immunity. Although B7-H4 binds an unknown receptor, it is thought to deliver an inhibitory signal to T-cells preventing their proliferation, cell cycle progression and interleukin-2 production. B7-H4 deficient mice are only minimally affected; suggesting B7-H4 is important in the fine tuning of the T-cell mediated immune response. B7-H4 is expressed on activated T-cells, B-cells, monocytes and dendritic cells. Aberrant expression has been associated with cancers of the lung, breast and ovary in humans. B7-H4 is expressed primarily on the membrane of lymphoid cells, and as an immunoinhibitory protein that interacts with receptors on the surface of T lymphocytes, it is involved in mediating cellular and humoral immune responses. Overexpression of B7-H4 is associated with certain malignancies, including ovarian and breast cancer, which may be a mechanism by which tumor cells suppress T cell immunity and facilitate tumor progression. Further, VTCN1 may be a useful biomarker for the early detection of ovarian cancer and Renal Cell Carcinoma (RCC).
仅用于科研。不用于诊断过程。未经明确授权不得转售。
生物信息学
蛋白别名: B7 family member, H4; B7 homolog 4; B7 superfamily member 1; B7-H4; B7h.5; co-stimulator molecule; costimulatory receptor; FLJ22418; Immune costimulatory protein B7-H4; immunoglobulin superfamily; B7 family; Protein B7S1; RP11-229A19.4; T cell costimulatory molecule B7x; T-cell costimulatory molecule B7x; unnamed protein product; V-set domain containing T-cell activation inhibitor 1; V-set domain-containing T-cell activation inhibitor 1; vtcn1; vtcn1 {ECO:0000312|EMBL:AAH95842.1}
基因别名: B7-H4; B7h.5; B7H4; B7S1; B7X; BC032925; PRO1291; RGD1311204; UNQ659/PRO1291; VCTN1; VTCN1
UniProt ID: (Human) Q7Z7D3, (Rat) Q501W4, (Mouse) Q7TSP5
Entrez Gene ID: (Human) 79679, (Rat) 295322, (Mouse) 242122